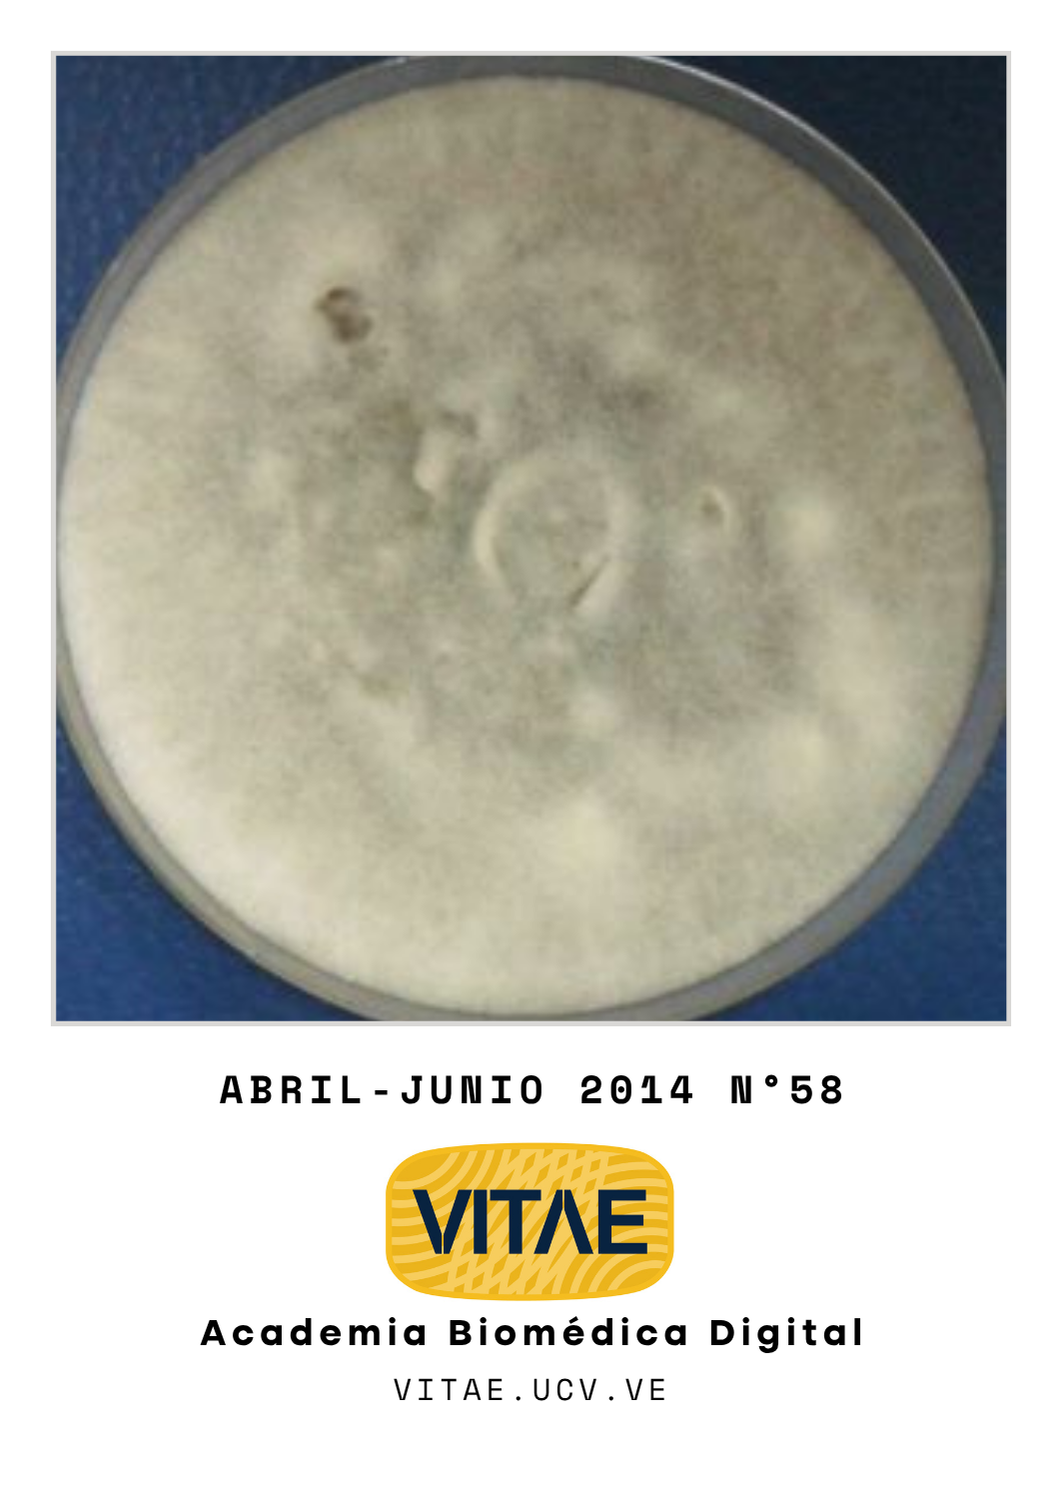

Octubre-Diciembre 2025
Vol. 4 Núm. 104
Con sumo agrado, la revista VITAE Academia Biomédica Digital de la Facultad de Medicina de la Universidad Central de Venezuela presenta su número 104, Diciembre 2025, dedicado íntegramente a la Hipertensión Arterial Crónica (HAC) y su impacto como problema de salud pública global.
Para este esfuerzo bibliográfico, hemos tenido el privilegio de contar con la Dra. Cristina López Sánchez, médico especialista en Medicina interna, profesora de Clínica Médica y Terapéutica y un referente nacional en el campo su especialidad como nuestro Editor Invitado. Su experiencia y visión han sido fundamentales para convocar un conjunto de autores y sus trabajos de investigación y revisión que abordan diferentes facetas de esta patología.

Julio-Septiembre 2025
Vol. 3 Núm. 103
El secreto médico en la era digital y la telemedicina
Dr. Héctor Arrechedera Zamorano ORCID: 0009 0001 7867 223
El ejercicio de la medicina es, en su esencia más profunda, un acto de fe. Un paciente, vulnerable y temeroso, se desnuda física y emocionalmente ante un extraño, revelando dolencias, hábitos y temores que tal vez no comparte con nadie más. Este vínculo sagrado, forjado en la intersección de la ciencia y la compasión, reposa sobre un pilar inquebrantable: la confidencialidad. Para el profesional de la salud, el secreto médico no es simplemente una norma legal o un código ético; es la manifestación más pura de su humanismo y la condición sine qua non de la relación médico-paciente.

Abril-Junio 2025
Vol. 2 Núm. 102
La inteligencia artificial y el futuro de las publicaciones científicas
Dr. Héctor Arrechedera Zamorano | ORCID: 0009 0001 7867 2232
Si bien el uso de inteligencia artificial (IA) en todos los ámbitos de la vida, indudablemente representa un avance científico de gran relevancia, a la hora de evaluar la producción científica y sus publicaciones puede representar un problema al plantearse interrogantes como integridad, la autoría y la esencia misma del proceso científico.
Hasta la presente, las investigaciones científicas y su publicación, traducen horas de investigación, análisis de datos, redacción meticulosa y revisión por pares. La IA ya está optimizando varias de estas etapas: desde la revisión bibliográfica automatizada que encuentra conexiones en vastos volúmenes de literatura, hasta la...

Enero-Marzo 2025
Vol. 1 Núm. 101
Primer Congreso Facultad Médica de la Universidad Central de Venezuela 2025
Dr. Héctor Arrechedera Zamorano | ORCID: 0009 0001 7867 2232
Los días 27, 28 y 29 de marzo de este año se celebrará el Primer Congreso de la Facultad Médica de la Universidad Central de Venezuela. En él se desarrollarán talleres precongreso, conferencias magistrales, simposios multidisciplinarios y reuniones con expertos. Asimismo, se presentarán trabajos de investigación desarrollados, por profesionales de las diferentes áreas de las ciencias de la salud, en esta casa de estudios. Este congreso tendrá una visión multi e interdisciplinaria desde la perspectiva científica y humanística de los grandes temas relacionados con la salud y la enfermedad.
El programa de desarrollará en los auditorios de los...

Octubre-Diciembre 2024
Vol. 4 Núm. 100
Número cien y seguimos…
Dr. Héctor Arrechedera Zamorano | ORCID: 0009 0001 7867 2232
La revista VITAE, Academia Biomédica Digital fundada el 3 de junio de 1999 publica en esta oportunidad su NÚMERO CIEN. Concebida como una revista de acceso abierto, es decir, que permite la revisión gratuita y sin restricciones a sus artículos en línea, inmediatamente después de su publicación se produce bajo el manto de la Facultad de Medicina de la Universidad Central de Venezuela.
Durante estos 25 años la Revista ha pasado por varias etapas en cuanto a su estilo, colaboradores y editores, pero siempre ha mantenido como norte informar a los profesionales de las ciencias de la salud en el sentido amplio de la palabra, sobre los avances más recientes en el campo de la medicina. Se han saldado problemas asociados a la poca...

Julio-Septiembre 2024
Vol. 3 Núm. 99
Migración de VITAE a OJS
Dr. Héctor Arrechedera Zamorano | ORCID: 0009 0001 7867 2232
En la línea de adaptación de la revista a los cánones actuales, sugeridos internacionalmente, nos es grato anunciarles que a través de la aprobación del proyecto “Reingeniería de la plataforma de la revista VITAE Academia Biomédica Digital-Migración a Open Journal Systems (OJS)” presentado en la convocatoria reciente del Consejo de Desarrollo Científico y Humanístico (CDCH) de la UCV, implementáramos la migración de VITAE hacia una nueva plataforma que aportará a nuestra publicación mayor visibilidad, eficiencia y calidad.
Esta migración se traducirá en nuevas políticas editoriales adaptadas a los nuevos tiempos, simplificación en la recepción de manuscritos, la gestión de revisiones por...

Abril-Junio 2024
Vol. 2 Núm. 98
El derecho a la salud
Dr. Héctor Arrechedera Zamorano | ORCID: 0009 0001 7867 2232
El derecho a la salud aparece como uno de los principios consagrados en la Declaración de los Derechos Humanos, proclamada por la Asamblea General de las Naciones Unidas en París, el 10 de diciembre de 1948. En su artículo 25 dice textualmente: “1. Toda persona tiene derecho a un nivel de vida adecuado que le asegure, así como a su familia, la salud y el bienestar, y en especial la alimentación, el vestido, la vivienda, la asistencia médica y los servicios sociales necesarios; tiene asimismo derecho a los seguros en caso de desempleo, enfermedad, invalidez, viudez, vejez u otros casos de pérdida de sus medios de subsistencia por circunstancias independientes de su voluntad. 2. La maternidad y la infancia tienen derecho a cuidados y asistencia...

Enero-Marzo 2024
Vol. 1 Núm. 97
El ascenso peligroso de la anticiencia
Desde el mismo momento que nació la ciencia, hace un poco más de 400 años, apareció la anticiencia. Con el tiempo, la construcción, alcance y manipulación de mentiras sobre la comunidad científica han estado bajo la influencia de la política, religión, sociedad, economía, entre otros. Algunos de estos relatos persisten aún después de ser comprobados científicamente como falsos.
La pandemia de COVID-19 ha tenido un impacto significativo en la sociedad y la percepción de la ciencia, con un aumento importante de la anticiencia. Las personas con opiniones anticientíficas no aceptan la ciencia como un método objetivo que pueda generar conocimiento universal. Es decir, quienes adoptan posturas anticientíficas cuestionan la validez y la objetividad de los métodos científicos y pueden manifestar...

Acumulado Enero - Diciembre 2023 (93 - 96)
Vol. 2 Núm. 93
Inteligencia Artificial y revistas científicas
Las revistas científicas o académicas han sido sometidas a numerosos cambios en los últimos años, primero con los desafíos y oportunidades del mundo digital y la Ciencia Abierta, luego durante la pandemia del COVID-19 con el advenimiento e incremento de los preimpresos, y recientemente debido a la creciente influencia de la Inteligencia Artificial (IA). Señalemos cómo la IA está impactando el mundo de las publicaciones científicas.
La IA está induciendo cambios en nuestras publicaciones en los siguientes aspectos:
- Evaluación y revisión de artículos científicos: Las herramientas de IA ofrecen eficiencias ilimitadas en la redacción de artículos y la revisión por pares. Ellas reducen la carga de trabajo de los revisores y editores, permitiéndoles centrarse en tareas de...

Acumulado Enero - Diciembre 2022 (89 - 92)
Vol. 1 Núm. 89
Desde hace más de una década, las revistas de casos clínicos se convirtieron en una prioridad en el área de salud. Los argumentos fueron muchos, pero el principal era la importancia particular en las distintas regiones del planeta que generaban resultados significativos. La pandemia del COVID-19 catapultó aún más su existencia y necesidad, con aportes grandes a la medicina individual y trasnacional.
Desde Vitae, Academia Biomédica Digital, queremos promover este tipo de publicación, por las razones que presentamos a continuación.
La relevancia de estas revistas se basa en las siguientes características:
- Nuevas observaciones:Los reportes de casos clínicos permiten identificar novedades clínicas
- Generación de hipótesis: Los reportes de casos o las series de casos permiten formular nuevas hipótesis que...

Acumulado Julio-Diciembre 2021 (87-88)
Vol. 3 Núm. 87
Editorial Vitae diciembre 2022
La revista “Vitae, Academia Biomédica Digital” se activa y toma su camino en el mundo del acceso abierto, después de la pandemia y el fallecimiento de nuestro Editor científico el Dr. José Alberto González Vega. Como un homenaje, dedicamos este número a su memoria.
Para ponernos al día, realizaremos dos números de acumulados. El presente número es el primero de los acumulados. Una vez terminados comenzaremos una nueva serie con el formato regular de la revista en 2023.
“Vitae, Academia Biomédica Digital”está indizada en Latindex, Bioline Internacional y Dialnet. Para aumentar su visibilidad,...

Abril-Junio 2021
Vol. 2 Núm. 86
"VITAE Academia Biomédica Digital" a lo largo de sus 23 años de publicación ha pasado por varias etapas. Cada una de ellas marcadas por un estilo, acorde con las indicaciones del Comité Internacional de Editores de Revistas Médicas (ICMJE) acompañado por el impartido por los editores que ha tenido esta revista.
Comenzamos en 1999 con una revista modesta, casi artesanal, pero a lo largo de estos años, la hemos visto crecer y posicionarse como una de las principales publicaciones del país. Dedicada principalmente a temas relacionados con ciencias de la salud, hasta la presente, se han publicado 86 números, más de 650 artículos y ha sido visitada por un número cada vez mayor de lectores. Está incluida en 3 índices y su visibilidad cada vez mayor la debemos precisamente a ello.
La creación en el año 2006 del cargo Editor científico, le...

Enero-Marzo 2021
Vol. 1 Núm. 85
Después de un periodo ausente por motivos ajenos a nuestra voluntad, retomamos con nuevos bríos la continuidad de publicación de VITAE Academia Biomédica Digital.
Queremos agradecer el interés y la dedicación de nuestros autores, árbitros y lectores y esperamos mantenerlos y aumentarlos en el futuro.
Gracias por su paciencia y los invitamos a continuar colaborando con sus trabajos en pro de la divulgación del conocimiento de y para los profesionales de nuestro país.

Edición especial COVID-19 Abril-Diciembre 2020
Vol. 2 Núm. 82
Edición especial COVID-19
Frente a la pandemia por COVID-19, el personal de salud enfrenta muchos retos, en virtud de la situación inédita que se les presenta. La celeridad del avance de la pandemia originó un caos inicial para responder a la emergencia, que ocasionó un problema de salud pública de gran magnitud, produciendo en todos los ámbitos temor ante lo desconocido. Paulatinamente su han despejado incógnitas preventivas, epidemiológicas, clínicas diagnósticas y terapéuticas que permiten paliar la situación, aunque aún la misma, se mantiene lejos del control como lo demuestran las cifras de afectación en todas partes del mundo.
Cada día diferentes grupos de trabajo comparten sus experiencias a través de publicaciones que permiten ir ordenando las evidencias que se generan en torno a esta novel enfermedad, siendo muy difícil para los...

Enero-Marzo 2020
Vol. 1 Núm. 81
Desde este espacio queremos anunciarles la puesta en marcha de un nuevo programa de la Facultad de Medicina de la Universidad Central de Venezuela, Llamada SOS, un servicio de telemedicina, gratuito y confidencial, que cuenta con un sistema innovador y eficiente para asistir a la población nacional.
El programa surge en el marco de la pandemia como una solución tecnológica para evitar las visitas innecesarias a los centros de salud. Por tanto, toda persona que presente síntomas o sospecha de infección por COVID-19 o de otras enfermedades, puede comunicarse, desde cualquier lugar de Venezuela, con Llamada SOS a través del 0212-313.56.60.
Invitamos a nuestros lectores, autores y árbitros a dar a conocer esta iniciativa que hoy colocamos a disposición de la población y agradecemos, como siempre, su confianza y...

Octubre-Diciembre 2019
Vol. 4 Núm. 80
Culminamos el 2019 con el número 80 de la revista, a pesar de las dificultades ha sido un año productivo y hemos trabajado con mucho esfuerzo para mantener la continuidad de publicación. Agradecemos a los autores por la confianza depositada en VITAE, a todos los lectores por su apoyo y a nuestros árbitros por su colaboración. Seguimos poco a poco aumentando la difusión y haciendo la revista más visible, muestra de ello son los números que les mostramos en esta imagen.

Julio-Septiembre 2019
Vol. 3 Núm. 79
Estimados lectores, a partir de este nuevo número queremos ofrecerles una sección sobre Informes de la salud en el mundo, donde queremos destacar enlaces de interés sobre documentos publicados por las organizaciones especializadas en gestionar políticas de prevención, promoción e intervención a nivel mundial en la salud
Los invitamos a enviarnos enlaces o documentos que consideren de interés para sus pares, tanto nacionales como internacionales.
Queremos así mismo agradecer el interés y la dedicación de nuestros autores, árbitros y lectores y esperamos mantenerlos y aumentarlos en el futuro.

Octubre-Diciembre 2018
Vol. 4 Núm. 76
Culmina para Vitae un año marcado con la partida de nuestro muy dilecto editor científico, el Dr. Jesús Alberto González- Vegas, quien siempre tan acertado en sus comentarios nos dejó una reflexión que mantiene su vigencia. El editorial de esa última edición abría con estas palabras:
“Con este número cerramos otro año de actividades, en medio de una muy severa crisis de salud en el país. Dicha crisis repercute seriamente sobre la ya reducida producción científica del sector salud y sobre las publicaciones científicas en el área, entre las cuales nos contamos.”
“Es por esto que es especialmente meritorio el esfuerzo que los autores realizan para llevar a cabo sus trabajos de investigación, a todos ellos estamos particularmente agradecidos, así como a aquellos que participan de la labor arbitral, contribuyendo a mejorar los manuscritos.”
Desde...

Julio-Septiembre 2018
Vol. 3 Núm. 75
Dr. Jacinto Convit García
Este 11 de septiembre se cumplieron los 106 años del nacimiento del Dr. Jacinto Convit García, médico y científico venezolano quien, a través de su trabajo, resaltaba la importancia de las vacunas en la prevención y tratamiento de enfermedades.
Destacado por su trabajo en el desarrollo de la vacuna contra la lepra, la leishmaniasis cutánea y sus aportes en el conocimiento de enfermedades infecciosas, como la Oncocercosis y Micosis profundas, obtuvo nombramientos en organizaciones de salud y premios que le valieron el reconocimiento a nivel Nacional e Internacional.
Desde Vitae Academia Biomédica Digital le recordamos con una entrevista publicada en el Número 16 (Julio-septiembre 2003).

Abril-Junio 2018
Vol. 2 Núm. 74
Las revistas científicas académicas, problemas y soluciones posibles (Vino viejo en odres nuevos)
Para este editorial hemos rescatado un texto de nuestro apreciado González-Vegas, quien en todo momento destacaba la importancia de las revistas nacionales y se mantenía al día con los programas, casos de éxito y las tecnologías relacionadas con las publicaciones electrónicas. Les dejamos sus reflexiones como parte de sus múltiples enseñanzas para quienes lo conocimos.
"Puede que los ideales que albergamos, nuestros sueños más anhelados y nuestras más fervientes esperanzas no lleguen a cumplirse mientras vivimos. Pero eso no importa. Saber que en tu día cumpliste con tu deber y estuviste a la altura de las expectativas de tus congéneres es por si misma una experiencia gratificante y un logro magnífico".
Nelson...

Enero-Marzo 2018
Vol. 1 Núm. 73
In memorian de Jesús Alberto González-Vegas
A las aladas almas de las rosas
del almendro de nata te requiero,
que tenemos que hablar de muchas cosas,
compañero del alma, compañero. Miguel Hernández
Estas líneas editoriales le correspondía escribirlas a nuestro Editor en Jefe y dilecto amigo, Dr. Jesús Alberto González-Vegas (JAGV), quien lamentablemente falleció el pasado mes de abril, dejándonos con un sentimiento de dolor por su súbita partida, pero a la vez felices de haber podido compartir, con él como amigo, más de una década de trabajo y de vida.
Jesús Alberto, era uno de esos gentiles caballeros que ya no abundan. Hombre recto, de profundas convicciones democráticas, amante de todo aquello que engrandece el espíritu; como es la libertad, la literatura, la amistad, la música clásica y las conversaciones...

Octubre-Diciembre 2017
Vol. 4 Núm. 72
Con este número cerramos otro año de actividades, en medio de una muy severa crisis de salud en el país. Dicha crisis repercute seriamente sobre la ya reducida producción científica del sector salud y sobre las publicaciones científicas en el área, entre las cuales nos contamos.
Es por esto que es especialmente meritorio el esfuerzo que los autores realizan para llevar a cabo sus trabajos de investigación, a todos ellos estamos particularmente agradecidos, así como a aquellos que participan de la labor arbitral, contribuyendo a mejorar los manuscritos.
El año que comienza, en medio de un proceso hiperinflacionario, no luce como el más auspicioso. Aun así confiamos en que podemos seguir recibiendo sus manuscritos y manteniendo el mismo estándar de calidad en la revista.
Dr. J. A. González Vegas

Julio-Septiembre 2017
Vol. 3 Núm. 71
Tiempos de cambio
La revolución digital y especialmente la expansión de Internet en escala mundial, ha traído como una de sus consecuencias, la posibilidad de adoptar nuevas formas en la diseminación del conocimiento científico, tanto en las plataformas digitales que han abaratado notablemente el costo de producción de las publicaciones científicas, y las han colocado al alcance de sociedades y de instituciones, permitiendo así una mayor difusión y visibilidad de los materiales publicados, como en la manera de concebir la actividad editorial y la validación de los productos científicos. Desde hace más de 20 años los Arxiv physics han utilizado una forma de comunicación conocida como “preprints”, esta práctica, que permite una mayor interacción entre la comunidad científica, y nuevas maneras de discusión y arbitraje, se ha extendido a otros campos como...

Abril-Junio 2017
Vol. 2 Núm. 70
Decimoctavo aniversario
La revista VITAE ha llegado a los diez y ocho años de publicación continua, el pasado 3 de junio. No ha sido fácil este tránsito, especialmente estos últimos años, la política gubernamental de estrangulamiento económico a las universidades autónomas, ha golpeado seriamente a la Universidad Central de Venezuela, de la cual somos parte. Sumado a esta situación que influye en todo el entorno universitario, hemos sido víctimas de ataques por piratas informáticos (hackers), los cuales dañaron los servidores donde se edita la revista y otros portales de SOS Telemedicina. Dejando de lado la ruindad que significa atacar unos servidores donde solo se almacena conocimiento útil a la comunidad, la reconstrucción de la data acumulada durante estos años, ha requerido de una gran cantidad de trabajo, lo cual ha interrumpido el cronograma...

Enero-Marzo 2017
Vol. 1 Núm. 69
Acceso abierto y libertad de expresión
Contitución de la República Bolivariana de Venezuela “Capítulo VI, De los Derechos Culturales y Educativos
Artículo 99. Los valores de la cultura constituyen un bien irrenunciable del pueblo venezolano y un derecho fundamental que el Estado fomentará y garantizará, procurando las condiciones, instrumentos legales, medios y presupuestos necesarios. Se reconoce la autonomía de la administración cultural pública en los términos que establezca la ley. El Estado garantizará la protección y preservación, enriquecimiento, conservación y restauración del patrimonio cultural, tangible e intangible, y la memoria histórica de la Nación.Los bienes que constituyen el patrimonio cultural de la Nación son inalienables, imprescriptibles e inembargables. La Ley establecerá las penas y sanciones para los daños...

Octubre-Diciembre 2016
Vol. 4 Núm. 68
De consentimiento informado y otras cosas.
“Una sociedad que no cuida a sus lectores, que no cuida sus libros y sus medios, que no guarda su memoria impresa y que no alienta el desarrollo del pensamiento es una sociedad culturalmente suicida.” Mempo Giardinelli (discurso de recepción del premio Rómulo Gallegos 1993)
Recomendamos la lectura del artículo: “Consentimiento informado en pacientes pediátricos hospitalizados: percepción por el personal de salud y los cuidadores”, el cual aparece en este número de la revista. De acuerdo a los autores hay un escaso número de profesionales de la salud y de cuidadores, que realmente entienden el consentimiento como un proceso en el cual participan por igual los miembros del equipo de salud y los familiares de los pacientes, y que este proceso debe redundar en beneficio de los...

Julio-Septiembre 2016
Vol. 3 Núm. 67
Luego del asalto continuado y el robo de equipos en el Instituto de Medicina Tropical, estamos nuevamente en línea con el número 67 de VITAE. Es nuestra profesión de fé que los esfuerzos de trabajo se ven recompensados, aunque a veces no sea en el plazo que queremos. Vemos con optimismo el desarrollo del proyecto SOS Telemedicina, llevado a cabo por esta UCV, que no siempre vence la sombra, pero si trae rayos de luz y de esperanza a aquellos que quieren verlos. La revista forma parte de este proyecto donde se realizan: consultas a distancia, cursos en línea para el mejoramiento profesional y académico del personal de salud, videoconferencias etc., totalmente gratis y de acceso abierto, que es una filosofía a la cual adherimos desde el comienzo del proyecto.
Lamentamos el fallecimiento del Dr Guillermo Whitembury, destacado científico, de larga tryectoria en el Instituto...

Abril-Junio 2016
Vol. 2 Núm. 66
De nuevo
“Decir que lo que es no es, o que lo que no es es, es lo falso; decir que lo que es es y que lo que no es no es, es lo verdadero”. Aristóteles.
Una revista científica biomédica es básicamente una plataforma para la difusión del conocimiento científico, que está respaldada por la opinión de los pares, quienes garantizan la idoneidad científica del material publicado. Las revistas científicas académicas Universitarias, son abiertas a todas las corrientes del pensamiento, y normalmente no registran posiciones políticas, aunque en oportunidades haya revistas que así lo hagan, p.ej. El caso de las revistas Nature y Science.
Son por lo tanto pertinentes las siguientes consideraciones: Nuestra revista que ha sufrido como la mayoría de las revistas científicas nacionales la falta de financiamiento por parte de los organismos gubernamentales y...

Enero-Marzo 2016
Vol. 1 Núm. 65
El asalto al conocimiento
Durante los últimos 17 años, hemos sido testigos de un sistemático desprecio por el conocimiento, especialmente el conocimiento científico, por parte de las autoridades gubernamentales; hemos asistido a la disminución progresiva de los presupuestos universitarios, instituciones donde se realiza la mayor parte de la investigación en el país, esto en una Venezuela con una de las tasas de inflación más alta en el mundo. Sufrimos la imposibilidad de cambiar las autoridades universitarias, en nombre de una fementida “igualdad” del claustro universitario con el personal administrativo y obrero que labora en la institución, la cual quiere ser impuesta. En estas condiciones no es difícil explicarse por qué ha disminuido la producción científica en Venezuela, y el éxodo de muchos científicos en busca de mejores oportunidades. A todo...

Octubre-Diciembre 2015
Vol. 4 Núm. 64
Con este número culminamos el 2015, un año lleno de serios problemas en el área de la salud, con una importante disminución en las condiciones de asistencia de las instituciones hospitalarias, así como en su dotación material y humana. Igualmente el deterioro de la situación universitaria, ha devenido en un factor negativo a lo interno. Aunque toda esta situación antecede a la disminución en los precios del petróleo, este último factor se suma negativamente a una situación que ya era comprometida.
Esta breve introducción sirve para resaltar el valor de los autores que tratan de mantener programas de investigación y desean compartirlos con nuestra audiencia, aún en estas condiciones. Su dedicación nos compromete cada vez más a seguir manteniendo este canal de comunicación que ya cuenta 16 años en línea. Agradecemos a todos aquellos que han servido de árbitros para la...

Julio-Septiembre 2015
Vol. 3 Núm. 63
SOS Telemedicina cursos en línea
En Venezuela, como en otras regiones de nuestro continente, existen notorias inequidades en salud, como consecuencia de diversos factores que limitan la posibilidad de recibir una atención médica oportuna y de calidad, entre ellos poco personal calificado, falta de infraestructura, equipamiento, y medicamentos, distancia física y cultural, ingresos reducidos, creciente costo de la atención médica.
Es conocido que los grupos con peores condiciones socioeconómicas no solo sufren una mayor carga de enfermedades, sino que, además, presentan enfermedades crónicas e incapacidades a edades más tempranas, tienen menos acceso a los servicios de salud y estos son de peor calidad.
Es en esta realidad donde la decisión de incorporar adecuadamente las tecnologías de información y comunicación (TIC),...

Abril-Junio 2015
Vol. 2 Núm. 62
16 años
La revista VITAE arriba a sus 16 años de vida. Lo que comenzó como una idea más bien utópica y adelantada a su tiempo: una publicación académica, solo en soporte digital y con acceso abierto para los lectores y sin costo para los autores, ha logrado consolidarse como un espacio para la difusión de la producción científica en el área de las ciencias de la salud, inclusive fuera de nuestras fronteras. Es importante enfatizar que la decisión sobre tener acceso abierto, es anterior al movimiento que culminó con la Declaración de Budapest en 2002 (1), así que nuestra revista fue pionera en ese campo, que ha demostrado ser de gran importancia para la libre difusión del conocimiento, sin más barreras que la calidad de los trabajos y su aprobación por pares.
En estos diez y seis años, la revista ha publicado más de 450 trabajos...

Enero-Marzo 2015
Vol. 1 Núm. 61
El Consejo de Desarrollo Científico y Humanístico de la UCV
El Consejo de Desarrollo Científico y Humanístico de la Universidad Central de Venezuela (CDCH-UCV), fue creado luego de 1958, en el período posterior al derrocamiento de la dictadura de Pérez Jiménez, a instancias del Rector Francisco De Venanzi, quien participaba de un modelo universitario en el cual la investigación científica era uno de los pilares fundamentales, alrededor de la cual se organizaban la docencia y la extensión. Consecuente con esta concepción la creación del CDCH-UCV como un organismo encargado de la promoción y difusión de la actividad científica universitaria y la formación de recursos humanos era una medida necesaria.
Hoy podemos darnos cuenta de lo valioso de esta idea y de sus resultados. La actividad editorial en materia científica de la UCV a lo...

Octubre-Diciembre 2014
Vol. 4 Núm. 60
El Programa “SOS Telemedicina para Venezuela”
El programa “SOS Telemedicina para Venezuela”, desarrollado en la Facultad de Medicina de la Universidad Central de Venezuela, se ha constituido en un ejemplo de buenas prácticas, para dar apoyo de medicina especializada, educación mediada por Tecnologías de Información y Comunicación (TIC) al personal de salud que se encuentra en zonas alejadas del país y divulgar contenidos de prevención en salud en las comunidades.
SOS Telemedicina ha desarrollado el software y ha provisto, sin costo para los usuarios, el hardware necesario para el programa de “Segunda Opinión en Salud”, de particular relevancia para comunidades aisladas como Cacurí, en el estado Amazonas o Los Ángeles del Tukuko, en la Sierra de Perijá en el estado Zulia, señalando así un importante camino para los programas de asistencia...

Julio-Septiembre 2014
Vol. 3 Núm. 59
Nuevamente sobre la situación de las revistas científicas
“Una sociedad que no cuida a sus lectores, que no cuida sus libros y sus medios, que no guarda su memoria impresa y que no alienta el desarrollo del pensamiento es una sociedad culturalmente suicida.”
Mempo Giardinelli
(discurso de recepción del premio Rómulo Gallegos 1993)
Nuevamente sobre la situación de las revistas científicas
Es lamentable tener que referirse permanentemente al mismo problema, prueba esta de que no ha sido posible solucionarlo, sino que por el contrario muestra síntomas de agravamiento. El reciente editorial del Dr Miguel Laufer, Editor de la Revista Interciencia, órgano de la Asociación Interciencia, la cual venía siendo editada en Venezuela durante las últimas cuatro décadas, y en el...
Abril-Junio 2014
Vol. 2 Núm. 58
Quince años
Vivir no es sólo existir, sino existir y crear, saber gozar y sufrir y no dormir sin soñar.
Descansar, es empezar a morir. Gregorio Marañón (1887-1960)
Nuestra revista cumple quince años de aparición continua y regular con este número 58. Lo que fue un sueño visionario de dos personas, creyentes en las potencialidades de las nuevas tecnologías de la información (TIC), es hoy una realidad tangible. En 1999 Héctor Arrechedera y María Dolores Fariñas, quienes poseen la afortunada combinación de poder soñar manteniendo los pies en la tierra, iniciaron desde el Centro de Análisis de Imágenes Biomédicas Computarizadas (CAIBCO), un proyecto pionero de publicación de una revista exclusivamente digital, en un momento en el cual el futuro de estas publicaciones no estaba claro. Su creencia en el poder de las nuevas tecnologías, resultó...

Enero-Marzo 2014
Vol. 1 Núm. 57
A manera de explicación
Nuestro país y nuestra universidad atraviesan tiempos difíciles que afectan seriamente el devenir académico. Las agresiones y constantes interrupciones en la actividad diaria universitaria, terminan retrasando muchas de las actividades de esta casa de estudios. Esta revista como muchos otros programas también ha sufrido retrasos tanto en su manejo, como en el flujo editorial y en la correspondencia con autores y árbitros, por lo que solicitamos la benevolencia de nuestros lectores. Reiteramos nuestra intención de mantener la continuidad que siempre hemos tenido y evitar la pérdida de la periodicidad, ya que entendemos que esto es muy importante para nuestros autores y lectores.
En este número contribuimos a difundir la: Guía de tratamiento antirretroviral de las personas que viven con el VIH/SIDA en Venezuela....

Octubre-Diciembre 2013
Vol. 4 Núm. 56
Una discusión necesaria
Dos declaraciones recientes, una del premio Nobel en Fisiología y Medicina 2013, Dr. Randy Schekman(1) y la otra del también premio Nobel en Física 2013 Dr. Peter Higgs(2). Nos parecen de gran importancia, porque apuntan a la naturaleza del debate sobre el futuro de las publicaciones científicas y de la manera como estas y los autores son evaluados. En la primera el Dr Shakman, denuncia la distorsión introducida en la práctica científica contemporánea por la existencia de las grandes revistas (top journals) específicamente, aunque no exclusivamente: Nature, Science y Cell (NSC), sus comentarios se fundamentan en los incentivos equivocados que se introducen al ser consideradas estas revistas como la meca de las publicaciones y ser los sitios donde se publica la mejor investigación, con el prestigio...

Julio-Septiembre 2013
Vol. 3 Núm. 55
Consideraciones sobre el proceso de arbitraje
Desde el comienzo de la comunicación científica, primero oral y luego de forma escrita, se ha aceptado la necesidad de que los resultados presentados al escrutinio público sean objeto de la crítica y posterior aceptación o rechazo por parte de los llamados "Pares" o "Iguales" de la respectiva disciplina científica, y más extensamente del resto de la sociedad. Una de las formas de institucionalización de esta práctica es lo que conocemos como el proceso de arbitraje de los trabajos científicos enviados a las numerosas revistas a través de las cuales se expresa la comunidad científica, con una diferencia notable cual es el hecho de que la aceptación o rechazo se produce antes de que los hallazgos hayan sido conocidos por el público. Sin entrar a discutir esta elitización del proceso de hacer del...

Abril-Junio 2013
Vol. 2 Núm. 54
La situación universitaria
Con este número de la revista cumplimos 14 años continuos, como una plataforma abierta y democrática para la difusión de contenidos de investigación en el área de ciencias de la salud, patrocinada por la Facultad de Medicina de la Universidad Central de Venezuela. Arribamos a este aniversario en un momento nada favorable para la universidad venezolana en general y para nuestra UCV en particular. Los ataques físicos contra la universidad, el estrangulamiento económico y la intención de liquidar su autonomía de pensamiento y la libre circulación e intercambio de todas las ideas, por parte del gobierno nacional, han lesionado seriamente su capacidad productiva y en consecuencia el número de publicaciones tiende a disminuir. Más que un hecho cuantitativo, debemos verlo como la disminución de las posibilidades de comprensión del...

Enero-Marzo 2013
Vol. 1 Núm. 53
Por una mejor Internet
La Organización de las Naciones Unidas aprobó en junio de 2011, el reporte del Comisionado Frank La Rue(1) relativo a la promoción y protección de las libertades de expresión y opinión, y ha declarado que el acceso a internet es uno de los Derechos Humanos, ya que "internet se ha convertido en un medio por el cual los individuos pueden ejercer su derecho a la libertad de expresión". Como ha ocurrido con la práctica de todos los derechos humanos, su desarrollo es desigual en el mundo y especialmente en los países más pobres o más regimentados políticamente. La presencia de Internet ha puesto al descubierto un gran potencial democratizador para la difusión del conocimiento, de manera universal y a muy bajo costo, y es por esto que es el blanco de ataques y afanes controladores por parte de gobiernos y grupos de opinión conservadores. En el...

Octubre-Diciembre 2012
Vol. 4 Núm. 52
Acceso Abierto ¿Quién debe pagar por el libre acceso a la información?
El movimiento llamado de "Acceso Abierto" comenzó oficialmente con la Iniciativa de Budapest, en diciembre de 2001, fue convocada una conferencia por la Free Online Scholarship, ahora conocida como la Open Society Institute, una fundación filantrópica creada por George Soros, la cual aprobó la declaración de Budapest sobre Acceso Abierto o de Libre Acceso. Vale la pena transcribir el comienzo de la declaración "Una vieja tradición y una nueva tecnología convergen para hacer posible un bien público sin precedente. La vieja tradición es el deseo de los científicos y académicos por publicar los frutos de su investigación en revistas académicas sin tener que pagar por ello, tan solo por el gusto de indagar y por el conocimiento. La nueva tecnología es Internet. El bien...

Julio-Septiembre 2012
Vol. 3 Núm. 51
Con gran entusiasmo presentamos el número 51 de la revista, luego de nuestro aniversario. Proseguimos con el mismo compromiso y comenzaremos una sección de cartas o comentarios al Editor. El propósito de esta sección es proveer un mecanismo de retroalimentación con nuestros lectores, donde puedan expresarse opiniones o comentarios relativos a la revista o a algún artículo en particular. La sección se conducirá con el decoro y educación necesarios para evitar insultos y modos incompatibles con el estilo del quehacer académico, y será moderada por el Editor. La correspondencia deberá ser dirigida a: editor.vitae@gmail.com
Igualmente comunicamos a nuestros lectores que pueden seguirnos en Twitter: @vitaeucv y en Facebook : Revista Vitae UCV
Dr. J. A. González Vegas

Abril-Junio 2012
Vol. 2 Núm. 50
Con la publicación de este número 50, la revista VITAE llega a su décimo tercer aniversario. Lo que comenzó como una apuesta al futuro en tiempos inciertos, es una realidad constituida. VITAE ha demostrado que era posible tener una revista sustentable en formato exclusivamente digital, en el área de la salud, con acceso abierto, arbitrada por pares e incluida en los índices importantes para este tipo de publicaciones, y así comenzó con el patrocinio de la Facultad de Medicina. La experiencia ha mostrado que la presencia en internet y el uso de las TICs, contribuye grandemente a la visibilidad de los contenidos de la revista, como lo atestiguan el casi millón de visitas recibidas, al menos desde el año 2006, cuando esto comenzó a monitorearse. Actualmente contamos con un número apreciable de lectores recurrentes cercano al 10% de las visitas anuales. Esta ha sido nuestra modesta...

Enero-Marzo 2012
Vol. 1 Núm. 49
Esta revista es un producto del esfuerzo del Centro de Análisis de Imágenes Biomédicas Computarizadas (CAIBCO) institución perteneciente a la Facultad de Medicina de la Universidad Central de Venezuela. Nuestra universidad está siendo víctima de políticas dictadas por el ejecutivo nacional, y que han significado severas restricciones presupuestarias. Los presupuestos asignados a las universidades no han variado en los últimos tres años, en un país que sufre una inflación cercana al 30% anual. Esta situación repercute duramente sobre los programas de investigación y de publicaciones, y si se suma a esto la errática asignación del subsidio a las revistas por parte del Fondo Nacional de Ciencia y Tecnología (Fonacit) tenemos una situación nada halagadora para la ciencia en el país. A pesar de esta situación, estamos comprometidos a mantener este espacio para la publicación de...

Octubre-Diciembre 2011
Vol. 4 Núm. 48
Llegamos al fin del año 2011 con el número 48 de la revista, pensamos que a pesar de las dificultades, ha sido un año productivo y se mantuvo la continuidad, lo cual consideramos muy importante. Agradecemos a todos los autores que han depositado su confianza en nosotros, y a todos nuestros lectores por su apoyo, igualmente a todos nuestros árbitros. Con este número aparece una nueva sección de Telemedicina, en vista de la importancia creciente de este campo. En esta sección encontrarán enlaces a publicaciones importantes en esta área, invitamos a nuestros lectores a enviarnos enlaces que consideren de interés, tanto nacionales como internacionales.
Dr. J. A. González Vegas

Julio-Septiembre 2011
Vol. 3 Núm. 47
Durante el mes de Noviembre, se realizó el Primer-Curso Videoconferencia: Atención Médica Integral Ambulatoria, patrocinado por la Facultad de Medicina de la Universidad Central de Venezuela, el Proyecto SOS Telemedicina para Venezuela, la Red Universitaria de Videoconferencia en Salud (RUVIS), la Corporación de Salud del Estado Nueva Esparta (CORPOSALUD), y el Programa de Nueva Esparta de la UCV.
La experiencia resultó exitosa y pudieron participar universidades y centros del exterior, y es una magnífica demostración de la importancia del uso de las TICS en el área de la salud, incluyendo programas de asistencia y de educación continuada a varios niveles. En este número de la revista publicamos un artículo sobre el desarrollo de la telemedicina en la República del Ecuador y a partir del próximo número comenzaremos a publicar un repositorio con materiales de interés en...

Abril-Junio 2011
Vol. 2 Núm. 46
Presentamos un nuevo número de nuestra revista, convencidos de la necesidad de mantener un vehículo de difusión para los productos del quehacer en ciencias de la salud. Vivimos tiempos difíciles que reclaman nuestra participación, y la nuestra es contribuir con materiales de calidad a la información y formación de nuestro personal de salud. Invitamos a todos los interesados a seguir participando de este esfuerzo mediante el envío de sus manuscritos, de su participación arbitral o como lectores y difusores de los contenidos que encuentren adecuados.
A partir del próximo número iniciaremos una sección sobre Telemedicina, con materiales de interés sobre lo realizado en esta área, que esperamos sea del agrado de nuestros lectores.
Invitamos a nuestros lectores a visitar la página: http://chagas.org.ve donde encontrarán...

Enero-Marzo 2011
Vol. 1 Núm. 45
La situación del financiamiento del sistema de revistas científicas por parte del estado, sigue atravesando por una etapa crítica, sin que termine de decidirse cuál será la política que se aplicará en definitiva. Es lamentable que organismos como el SINADIB (Sistema Nacional de Documentación e Información Biomédica), creado en 1973 y que ha realizado una notable labor a favor de la preservación de nuestro acervo científico, se vean seriamente afectados en su funcionamiento por falta de fondos, en un país que lo menos que puede alegar es carencia de recursos. Padecemos de una suerte de esquizofrenia donde se le da valor a la publicación de artículos en revistas nacionales y por el otro lado se es mezquino en las asignaciones para que estas puedan funcionar adecuadamente. Esperamos que la situación mejore de manera sustancial y nuestras revistas puedan seguir siendo lo que...

Octubre-Diciembre 2010
Vol. 4 Núm. 44
Estimados amigos,
Les ofrecemos nuestras excusas a los autores y a nuestros lectores, por la tardanza en la aparición de este número. Las causas fueron diversas y no vale la pena discutirlas en detalle. Queremos reiterar nuestra disposición a mantener la periodicidad acostumbrada. Esto es especialmente importante en la situación actual de nuestras revistas, ya que una política gubernamental miope, ha venido restringiendo los subsidios que se otorgaban a través del Fonacyt, ente financiador, dependiente del Ministerio de Ciencia y Tecnología. Varios investigadores y especialmente el Dr Jaime Requena han llamado la atención sobre la paulatina disminución en la producción científica nacional, consecuencia en nuestra opinión de políticas científicas equivocadas y del estrangulamiento económico que padecen nuestras universidades, lo cual limita seriamente su capacidad...

Julio-Septiembre 2010
Vol. 3 Núm. 43
Recientemente se celebró en Caracas una importante reunión de Editores de Revistas Científicas, donde tuvimos la oportunidad de exponer e intercambiar puntos de vista sobre el presente y el futuro de nuestras revistas. La situación actual no es la más alentadora, por un lado la incertidumbre sobre los financiamientos de ayuda a las publicaciones, y por el otro, los problemas presupuestarios de nuestras universidades que repercuten seriamente sobre los programas de investigación, de cuyos productos dependemos. Todo esto nos obliga a duplicar los esfuerzos para que nuestras revistas sigan funcionando, apareciendo regularmente, y sean ofrecidas en acceso abierto. Por nuestra parte seguimos asumiendo el compromiso de mantener la publicación, con los mismos estándares de calidad y de libre acceso. Invitamos a nuestros lectores a enviar sus manuscritos para evaluación y eventual...

Abril-Junio 2010
Vol. 2 Núm. 42
Con este número nuestra revista arriba a los once años de vida, toda una gran experiencia para un proyecto que comenzó como una apuesta hacia el futuro desarrollo que tendrían las publicaciones electrónicas. Luego de once años hemos logrado demostrar que es posible mantener una revista que se publica solo en formato electrónico, y que es éste un medio adecuado para la comunicación científica, lo cual no era claro al comienzo de la revista. La utilización de internet y la política de acceso abierto, han permitido aumentar la visibilidad de la revista, mucho más allá de lo que es posible con una revista impresa y a menores costos. El pequeño mapamundi en nuestra página muestra claramente que la revista es consultada en prácticamente todo el mundo, y sabemos que el número de visitas se ha ido incrementando cada año. Nuestro compromiso permanente es ofrecer una revista de calidad...

Enero-Marzo 2010
Vol. 1 Núm. 41
Queremos aprovechar esta oportunidad para comentar el inicio formal de la plataforma del proyecto SOS Telemedicina para Venezuela, la cual fue instalada en el Estado Nueva Esparta, con la presencia de autoridades del estado y autoridades universitarias de la Universidad Central de Venezuela. Creemos que esta iniciativa es de gran importancia para el país y que su puesta en marcha y la evaluación subsiguiente serán una gran contribución a la solución de los problemas médico-sanitarios del país. Adicionalmente el proyecto está en ejecución en comunidades remotas (Cacurí, Estado Amazonas), donde hay miembros de la comunidad que han sido entrenados en el uso de la aplicación y quienes mantienen contacto permanente. Un próximo número de la revista analizará diferentes aspectos de este proyecto.
Como siempre agradecemos a nuestros lectores, autores y árbitros por su...

Octubre-Diciembre 2009
Vol. 4 Núm. 40
Hemos concluido otro año de vida, la revista ha aumentado su difusión, medida por el número de visitas a nuestra página, (189.893) esto representa un incremento de 12,37% en relación al año anterior. Poco a poco la revista es cada vez más visible, y alcanza mayor difusión en escala internacional. Es nuestro propósito el mejorar constantemente la calidad de los materiales publicados, y colaborar con nuestros autores en que logremos esta meta común. El año 2010 debemos introducir cambios en el software de edición y gestión de la revista, lo cual esperamos redunde en una mayor eficiencia en los procesos y disminuya el tiempo para la publicación de los artículos. Saludamos como un gran logro del proyecto SOS Telemedicina para Venezuela la próxima apertura de 15 centros en el Estado Nueva Esparta, los cuales indudablemente contribuirán tanto a mostrar las ventajas de la telemedicina...

Julio-Septiembre 2009
Vol. 3 Núm. 39
Estimados lectores, en nuestro afán de ir introduciendo mejoras progresivas en la difusión del conocimiento bio-médico, en este número encontrarán (artículo sobre Brucelosis humana), que hemos comenzado la inclusión de pequeños videos como parte de los artículos. Pensamos que esto ofrece una oportunidad de presentar en los artículos aquellos materiales referentes a procedimientos técnicos, cuya comprensión se facilita por la visualización dinámica del material.
Queremos invitar a nuestros lectores y autores a continuar acompañándonos en la revista, tanto con sus contribuciones como con sus comentarios siempre bienvenidos.
Dr. J. A. González Vegas

Abril-Junio 2009
Vol. 2 Núm. 38
Con este número, nuestra revista cumple diez años de presencia continua en internet. Lo que comenzó siendo un intento de aplicación de nuevas tecnologías de información en la difusión de conocimiento en el área de salud, es ahora una experiencia consolidada, gracias a la colaboración de nuestros autores, árbitros y un número de creciente de lectores. Para celebrar el aniversario la revista organizó un acto cuyo evento central fue la conferencia “Darwinerías”, dictada por el Dr. Francisco Ruiz Manresa, y la cual reproducimos en este número. Esperamos continuar en el camino que transitamos, y seguir siendo un vehículo idóneo para la publicación de conocimiento original producido en Venezuela y en Latinoamérica, y fuente de conocimientos de calidad para la permanente actualización de los profesionales en el área de salud. VITAE asimismo forma parte de los proyectos realizados en el...

Enero-Marzo 2009
Vol. 1 Núm. 37
Con el próximo número de nuestra revista cumpliremos diez años de presencia ininterrumpida en la web, donde podemos afirmar que hemos logrado construir un nicho gracias, entre otras razones a la filosofía de acceso abierto a los contenidos de la revista, que hemos mantenido desde su fundación. La revista es uno de los proyectos que desarrolla el CAIBCO (Centro de análisis de imágenes biomédicas computarizadas) de la Facultad de Medicina de la Universidad Central de Venezuela, y conjuntamente con los proyectos SOS telemedicina y SIES (Sistema de información y educación en salud) constituye un apreciable recurso para la difusión de las investigaciones que se realizan en el área de la salud, y creemos que es de gran ayuda a todos los involucrados en esta actividad. Esperamos seguir contando con el apoyo de nuestros autores, árbitros y lectores quienes contribuyen a hacer la labor de...

Julio-Diciembre 2008
Vol. 3 Núm. 36
Presentamos este número (doble) de la revista, con el cual cerramos el año 2008. Ha sido un período productivo, con algunos cambios en la visibilidad de la revista, de acuerdo al monitoreo de Google Analytics la revista ha tenido durante el año 2008, un incremento de 60.000 visitas en relación al año 2007. Asimismo como puede observarse en el recuadro al final de la portada, su visibilidad es prácticamente universal. Estos hechos nos motivan a seguir en este esfuerzo, con la ayuda de ustedes, tanto autores como lectores, de manera de seguir siendo un espacio de acceso abierto para la publicación de trabajos en el área de la salud. Para este próximo año, esperamos mejorar el software de edición y gestión de la revista, con el fin de mejorar la eficiencia. En este número publicamos en nuestra sección "De interés" un trabajo de los Dres Lucena y Coronel sobre la cirugía endoscópica...

Abril-Junio 2008
Vol. 2 Núm. 35
Este número de la revista recoge una serie de trabajos y observaciones de nuestros médicos, que muestran el interés de nuestros autores por la divulgación del conocimiento producido en la región y de la necesidad de hacer del conocimiento de la comunidad relacionada con la salud, la ocurrencia de nuevas patologías o de maneras diferentes de presentarse algunas de las ya conocidas. Saludamos este esfuerzo y mantenemos abiertas las puertas de la revista a todas estas manifestaciones, que estamos convencidos contribuyen a mejorar el nivel académico de nuestras instituciones. Como nuestros lectores podrán apreciar hemos agregado un pequeño programa (ClustrMaps), el cual refleja las visitas a la revista y las zonas desde donde éstas son realizadas.
Queremos así mismo comunicarle a nuestra audiencia la marcha del proyecto;“SOS Telemedicina para Venezuela", el cual es llevado...

Enero-Marzo 2008
Vol. 1 Núm. 34
Ofrecemos excusas a nuestros lectores, por la tardanza en la aparición del presente número. El retardo se debió a que la revista debió ser migrada a nuevos servidores, ahora situados en la propia sede del Caibco. Este cambio, necesario, permitirá un mejor control y una pronta resolución de los problemas que puedan presentarse en el futuro.
Debido a la gran difusión e importancia que viene adquiriendo la iniciativa de acceso abierto a la cual esta revista suscribe, reproducimos un documento de interés, (en inglés) para que los autores se familiarizen con la iniciativa y sus aspectos legales.

Octubre-Diciembre 2007
Vol. 4 Núm. 33
El Proyecto SIES
El Caibco, sección de investigación de la facultad de Medicina de la Universidad Central de Venezuela, y entidad responsable de la publicación de esta revista, ha dado comienzo a un nuevo proyecto en el marco de la Ley Orgánica de Ciencia, Tecnología e Innovación. El proyecto en cuestión, denominado Sistema de Información y Educación en Salud (SIES), tiene por objeto desarrollar, utilizando las tecnologías de información y comunicación, dos portales con contenidos sobre salud, en todas las áreas, estimulando la participación tanto de los especialistas que trabajan en el área de la salud, como de los usuarios. El respaldo académico de la información presentada, estará garantizado por las contribuciones de los numerosos especialistas con que cuenta nuestra universidad y su prestigio institucional. Asimismo una supervisión y arbitraje...

Julio-Septiembre 2007
Vol. 3 Núm. 32
Un análisis del comportamiento de la revista y de las visitas a ésta, muestra algunas observaciones de interés sobre las nuevas tendencias en la difusión y búsqueda de información en el área biomédica, que bien vale la pena tener en cuenta. Durante el período del 15 de julio de 2007 al 15 de enero de 2008, la revista recibió 47.979 visitas, prácticamente de todo el mundo, y especialmente de Venezuela (17.439), México (8.332), España (4.968), Colombia (3.459), Peru (3.060), Argentina (2.701), Chile (2.188) y USA (883). De estas visitas 5.336 son de usuarios recurrentes, y 42.643 son nuevos usuarios.Esto habla favorablemente del aumento de la visibilidad de los contenidos publicados, lo cual sería muy difícil de alcanzar con revistas impresas, y de la existencia de un núcleo importante de lectores asiduos de la revista. Así mismo es importante destacar el hecho de una audiencia...

Abril-Junio 2007
Vol. 2 Núm. 31
En este número, incluimos los requerimientos uniformes para manuscritos biomédicos. Es este un valioso documento con información sobre varios aspectos del proceso de edición, el papel de los editores y los problemas éticos involucrados en todo el proceso de producción de conocimientos. Esta revista apoya la iniciativa de Vancouver y trata de ceñirse a estas normas, por lo cual consideramos de gran utilidad su lectura.
Nuevamente celebramos este año que el portal CAIBCO y su revista VITAE hayan quedado como primer finalista en la sección de e-ciencia de los World Summit Awards, mención que nos llena de orgullo, por ser un reconocimiento al esfuerzo por tener contenidos en internet que estén validados institucionalmente.
Dr. J.A. González Vegas
Editor científico.

Enero-Marzo 2007
Vol. 1 Núm. 30
Después de algunos tropiezos que han retrasado la aparición de la revista, presentamos el número 30, correspondiente al año 2007, esperamos regularizar la aparición de los siguientes números en el curso de este año. Estamos empeñados en disminuir los tiempos de arbitraje y de publicación de los manuscritos que sean aceptados.
En este esfuerzo es importante que los autores cumplan cabalmente con las normas de la revista en lo relativo a seguir fielmente las instrucciones para los autores. En un futuro próximo revisaremos las instrucciones a los autores, de manera de hacerlas lo más detalladas y útiles que sea posible.
Asimismo queremos que nuestros árbitros, haciendo uso de las ventajas y la rapidez del correo electrónico, reduzcan el tiempo que toma la revisión de los trabajos. Tenemos la intención de ir introduciendo pequeños cambios, que sumados hagan...

Octubre-Diciembre 2006
Vol. 4 Núm. 29
Editorial
Hace 8 años, en edición de fecha junio / agosto de 1999, "VITAE Academia Biomédica Digital" apareció por vez primera. En este período de tiempo hemos publicado en la Internet 29 números, reuniendo más de 200 artículos originales, de revisión, 28 casos clínicos, pautas, consensos y las informaciones de las secciones fijas de la revista. Ese conjunto de documentos constituye una contribución relevante a la construcción de la sociedad del conocimiento en salud, desde países de habla hispana.
En VITAE hemos hecho esfuerzos continuos por elevar la calidad de la revista, optimizando su arbitraje, logrando su indización en más de 10 índices internacionales y alcanzando su reconocimiento en los baremos de ingreso a los postgrados de las Facultades de Medicina de Venezuela, así como en los sistemas de estímulos a los...

Julio-Septiembre 2006
Vol. 3 Núm. 28
Una oportunidad...
La investigación en salud, el fortalecimiento de recursos humanos y la promoción y divulgación de las actividades biomédicas realizadas en el país, pudieran recibir un significativo apoyo económico si logramos, desde las universidades nacionales, aprovechar los escenarios propicios establecidos por la ley Orgánica de Ciencia, Tecnología e Innovación (Locti).
Dicha ley establece la obligatoriedad de inversión en ciencia, tecnología e innovación por parte de las empresas privadas cuyos ingresos anuales superen las 100.000 Unidades Tributarias.
En el artículo 42 de esta Ley Orgánica se establecen las actividades susceptibles a ser financiadas por la Locti, así como los mecanismos o procedimientos para obtener de las empresas financiamiento para proyectos de investigación en el marco de esta reciente obligación...

Abril-Junio 2006
Vol. 2 Núm. 27
Nueva imagen gráfica
Hace 10 años inauguramos, con el apoyo del Decanato de la Facultad de Medicina de la Universidad Central de Venezuela, el Centro de Análisis de Imágenes Biomédicas Computarizadas (CAIBCO).
A lo largo de esta década hemos impulsado el desarrollo de aplicaciones Web, mediante el uso de las Tecnologías de Información y Comunicación (TICs), que permiten la diseminación gratuita del conocimiento en salud que se genera en nuestra región. Todo esto, gracias al apoyo de nuestra comunidad universitaria y de nuestros editores de Área.
Uno de los productos que desde este espacio hemos generado ha sido "VITAE Academia Biomédica Digital", que es la primera revista electrónica biomédica creada en Venezuela. Luego de 6 años de existencia, se encuentra registrada en 10 bases de datos internacionales y ofrece acceso...

Enero-Marzo 2006
Vol. 1 Núm. 26
S.O.S. Telemedicina para Venezuela
Colocar las tecnologías de información al servicio de la salud ha permitido a numerosos países tener una gestión sanitaria más ágil, profesionales de salud mejor capacitados y pacientes que se benefician del uso de estos recursos. La telemedicina se ubica como un elemento clave que reúne un conjunto de nuevas tecnologías para ofrecer una atención especializada al paciente donde quiera que éste se encuentre.
La telemedicina, más que una herramienta tecnológica y asistencial, es un instrumento de cambio organizativo que obliga a las instituciones a pensar de otra manera, a pasar por alto las diferencias entre los niveles asistenciales y fomentar la integración de la información que se tiene de los pacientes y la cooperación entre los profesionales.
La implantación de un sistema de telemedicina...

Octubre-Diciembre 2005
Vol. 4 Núm. 25
Herramienta del conocimiento
En nuestro país, las universidades y centros de investigación son los generadores del conocimiento científico, en particular en el área biomédica.
Los docentes, residentes de postgrado y estudiantes de pre-grado, discuten a diario casos clínicos relevantes, generan artículos de revisión, escriben trabajos de ascenso o Trabajos Especiales de Investigación (TEI), los cuales, a pesar de ser relevantes, nunca llegan a ser publicados. De esta forma, gran parte de una valiosa información queda confinada dentro de las paredes de un servicio o de un postgrado, sin la posibilidad de ser compartidos con la comunidad hispanoparlante interesados en conocimientos en salud.
Hoy, las tecnologías de información y el uso de Internet nos permiten romper las barreras geográficas y construir colectivamente la sociedad...

Julio-Septiembre 2005
Vol. 3 Núm. 24
Acceso abierto a la literatura biomédica
La literatura científica y en particular la biomédica, se encuentra monopolizada por las grandes editoriales. Como consecuencia de esto, las suscripciones a las revistas especializadas son cada día más costosas, lo que ha hecho que muchas universidades y bibliotecas no puedan seguir pagando las suscripciones; negándose el acceso al conocimiento actualizado.
Hoy, la tradicional voluntad de los científicos de publicar sus trabajos, sólo por el bien de la difusión del conocimiento, se conjuga con las nuevas tecnologías que representan Internet. La distribución electrónica de artículos de revistas científicas arbitradas por pares (peer review), a escala mundial, permite el acceso de forma gratuita y sin restricciones para científicos, universitarios, estudiantes y otras personas interesadas. Todo para...

Abril-Junio 2005
Vol. 2 Núm. 23
VITAE, Academia Biomédica Digital Obtuvo el Premio Arístides Bastidas como el mejor sitio en la red
El trabajo realizado por VITAE, Academia Biomédica Digital para la divulgación de conocimiento a través de Internet, acaba de ser reconocido al otorgársele el “Premio Municipal de Comunicación Social Científico 2005 Arístides Bastidas".
Un jurado conformado por representantes del Círculo de Periodismo Científico, las Escuelas de Comunicación Social, el Colegio Nacional de Periodistas y la División de Cultura del Municipio Libertador, seleccionó, entre una amplia muestra de portales de divulgación científica venezolanos, a VITAE como merecedor de este reconocimiento.
Se premia de esta forma a un proyecto editorial desarrollado en la Facultad de Medicina de la Universidad Central de Venezuela que, utilizando las...

Octubre-Diciembre 2004
Vol. 4 Núm. 21
Hoy en día, es reconocida universalmente, la importancia de las tecnologías de información y comunicación ofrecidas por Internet. La comunidad científica acude con frecuencia a la World Wide Web, para actualizar sus conocimientos en las áreas de su competencia, y para revisar los últimos contenidos de las revistas científicas de su preferencia, que cuentan con acceso en línea.
Es aquí donde VITAE Academia Biomédica Digital cobra más importancia que nunca, al ser una revista de formato netamente electrónico, de fácil acceso y con contenido científico de elevada calidad, que difunde los conocimientos generados en nuestras universidades y centros de investigación, hacia una comunidad conformada por investigadores, estudiantes y profesionales de la salud. De esta forma, contribuye con la generación de espacios de discusión, así como en la formación continua de los...

Julio-Septiembre 2004
Vol. 3 Núm. 20
La publicación número 20 de la revista electrónica VITAE, enmarca los cinco años de ininterrumpida labor haciendo uso de las tecnologías de información, para dar a conocer con el aval de la Universidad Central de Venezuela y de forma gratuita: 170 artículos de revisión, 40 casos clínicos de interés y una variedad de contenidos en salud generados en nuestra región.
VITAE ha demostrado ser a lo largo de estos años un proyecto editorial viable, arbitrado, económico y de amplia receptividad. La valiosa y continua colaboración de los médicos, residentes de los postgrados e investigadores básicos han hecho posible su permanencia en el tiempo y trabajamos fuertemente para que estos sean sólo los primeros cinco años de su existencia en el camino a consolidarnos como una opción de publicación de los profesionales de la salud en la región de habla hispana.
Quiero...

Abril-Junio 2004
Vol. 2 Núm. 19
5 Años de VITAE
Llegamos con este número 19 de VITAE a los primeros 5 años ininterrumpidos de esta publicación electrónica, pionera en la divulgación de contenidos de salud certificados en Internet.
El público al que hemos dirigido la revista ha sido el de profesionales y estudiantes de la salud de habla hispana, quienes han encontrado en VITAE, contenidos gratuitos a texto completo, que han sido arbitrados y avalados por un cuerpo de editores de área de reconocida trayectoria en cada una de sus especialidades.
VITAE ha sido un proyecto editorial que ha resultado ser una escuela para todos los que hemos apostado por esta revista electrónica, como una opción válida para dar a conocer de una manera rápida y económica contenidos generados en nuestra región.
Gracias a esta convicción hemos logrado tener entre nuestros...

Enero-Marzo 2004
Vol. 1 Núm. 18
La Telemedicina se define como "el suministro de servicio de atención sanitaria en los que la distancia constituye un factor critico, por profesionales que apelan a las tecnologías de la información y de la comunicación con objeto de intercambiar datos, para hacer diagnósticos preconizar tratamientos y prevenir enfermedades y heridas, así como para la formación de profesionales de atención de salud y en actividades de investigación y evaluación con el fin de mejorar la salud de las personas y de las comunidades en que viven". Organización Mundial de la Salud (OMS)
El sector de la salud ha sido uno de los constituyentes de la sociedad más dinámicos en lo que se refiere a la incorporación de modernas tecnologías para el apoyo de la labor de promoción de la salud, prevención de las enfermedades y atención de los pacientes. Para cumplir su misión, las...

Octubre-Diciembre 2003
Vol. 4 Núm. 17
El conocimiento del pasado constituye una fuente inagotable de aprendizaje. En este sentido la Historia de la Medicina de los países latinoamericanos, nos permite conocer, valorar y aprender las experiencias que, en nuestra región, dieron lugar al desarrollo de las distintas especialidades; así como los esfuerzos que personajes pioneros realizaron para la consolidación de cátedras, postgrados y grupos de investigación. Es un universo lleno de acontecimientos, personajes e instituciones que han sido importantes en el proceso de modernización de la región.
Es por esta razón que VITAE ha decidido abrir una nueva Sección en la revista, que hemos denominado "Medicina en el Tiempo". Con este nuevo espacio nos proponemos realizar un trabajo sistemático a fin de producir y divulgar electrónicamente información de valor sobre lo que ha sido el desarrollo de la medicina...

Enero-Marzo 2003
Vol. 1 Núm. 14
Constancia, perseverancia, tenacidad y persistencia, son algunas de las características que en estos tres años han animado a VITAE Academia Biomédica Digital a perseguir un único objetivo: dar a conocer, a través de Internet, contenidos de valor generados en Iberoamerica, para el beneficio de los profesionales y estudiantes interesados en el área de la salud.
Este empeño académico, que elaboramos desde la Universidad Central de Venezuela, tiene su compensación y esto se evidencia en esta nueva edición de VITAE. Gracias al trabajo conjunto del cuerpo de Editores de Área, de los autores de las contribuciones, y del equipo del CAIBCO, podemos exhibir con orgullo a la comunidad, uno de los números mejor logrados.
Sin menoscabo de la calidad del resto de las contribuciones que hoy presentamos, nos sentimos extremadamente honrados al haber...

Octubre-Diciembre 2002
Vol. 4 Núm. 13
Constancia, perseverancia, tenacidad y persistencia, son algunas de las características que en estos tres años han animado a VITAE Academia Biomédica Digital a perseguir un único objetivo: dar a conocer, a través de Internet, contenidos de valor generados en Iberoamerica, para el beneficio de los profesionales y estudiantes interesados en el área de la salud.
Este empeño académico, que elaboramos desde la Universidad Central de Venezuela, tiene su compensación y esto se evidencia en esta nueva edición de VITAE. Gracias al trabajo conjunto del cuerpo de Editores de Área, de los autores de las contribuciones, y del equipo del CAIBCO, podemos exhibir con orgullo a la comunidad, uno de los números mejor logrados.
Sin menoscabo de la calidad del resto de las contribuciones que hoy presentamos, nos sentimos extremadamente honrados al haber...

Julio-Septiembre 2002
Vol. 3 Núm. 12
El impacto generado hoy por las publicaciones electrónicas especializadas y la posibilidad de acceder a ellas libremente en Internet, constituye uno de los debates más interesantes que está viviendo la comunidad científica en los últimos años.
Las publicaciones electrónicas especializadas están determinando en la actualidad el flujo de una significativa porción de la información científica a escala global, al ofrecer una visibilidad libre y amplia, aminorar los costos, reducir el tiempo entre la generación del conocimiento y su publicación, rompiendo así con algunas barreras impuestas a la ciencia al momento de trasladarse al terreno de la comunicación.
A pesar de todos los beneficios que implica la publicación en formato digital, existen poderosos intereses en contra de la corriente que promueve la presentación de artículos de investigación a texto...

Abril-Julio 2002
Vol. 2 Núm. 11
El impacto generado hoy por las publicaciones electrónicas especializadas y la posibilidad de acceder a ellas libremente en Internet, constituye uno de los debates más interesantes que está viviendo la comunidad científica en los últimos años.
Las publicaciones electrónicas especializadas están determinando en la actualidad el flujo de una significativa porción de la información científica a escala global, al ofrecer una visibilidad libre y amplia, aminorar los costos, reducir el tiempo entre la generación del conocimiento y su publicación, rompiendo así con algunas barreras impuestas a la ciencia al momento de trasladarse al terreno de la comunicación.
A pesar de todos los beneficios que implica la publicación en formato digital, existen poderosos intereses en contra de la corriente que promueve la presentación de artículos de investigación a texto...

Enero-Marzo 2002
Vol. 1 Núm. 10
El comienzo de cada año, como todo inicio de un ciclo, es tiempo para plantearse buenos propósitos, rectificar los errores del pasado y planificar, con entusiasmo y energía, el nuevo tiempo.
Nuestro equipo de trabajo en la Universidad Central de Venezuela no escapa a este impulso ordenador. Es así como enero nos encuentra, por una parte, terminando de preparar el décimo número de VITAE, y por otra, impulsando proyectos e ideas, los cuales apuntan hacia la búsqueda de mejores maneras de aprovechar las diferentes alternativas de comunicación, ofrecidas por Internet, para colocar contenidos de valor.
Actualmente, estamos concentrados en la implementación de nuevas vías que permitan consolidar a VITAE como una propuesta de calidad en cuanto a información de salud se refiere, orientando nuestros mayores esfuerzos hacia la máxima utilización de este espacio para...

Octubre-Diciembre 2001
Vol. 4 Núm. 9
Arribamos al noveno número de la revista biomédica digital VITAE. Un esfuerzo editorial electrónico por colocar en Internet, desde Latinoamérica, contenidos de valor dirigidos a profesionales y estudiantes de la salud, que representen un aporte a la educación continua y una vía para la divulgación del conocimiento generado en los paises iberoamericanos.
Nos anima el hecho de haber logrado en estos años, no sólo despertar el interés de diferentes colegas, dentro de nuestras fronteras. Fuera de ellas, investigadores y especialistas han encontrado en esta publicación un medio calificado para dar a conocer parte de su trabajo. Es así como se ha podido incluir, contribuciones provenientes de Argentina, Cuba, Perú, Chile, Brasil, España, además de los trabajos realizados en Venezuela.
Esto ha sido posible, gracias a la cooperación de nuestros Editores de Área,...

Junio-Agosto 2001
Vol. 3 Núm. 8
Hace exactamente dos años presentamos en el auditorio del Hospital Universitario de Caracas, el lanzamiento del primer número de VITAE. Los aniversarios, como cierre de un ciclo, inevitablemente están asociados a la necesidad de realizar un balance y un recuento de los logros alcanzados, como manera de releer nuestra historia reciente y como una forma de prepararnos ante las tareas que nos plantea el futuro.
VITAE "Academia Biomédica Digital" surgió de la iniciativa de un grupo de profesores de la Facultad de Medicina de la Universidad Central de Venezuela (UCV), quienes aprovechando las ventajas que proporciona Internet, nos planteamos como objetivo divulgar contenidos biomédicos de valor generados en Venezuela y otros países de la región, dirigidos a profesionales y estudiantes de la salud de habla hispana.
Contamos, para ese entonces, con la experiencia...

Diciembre 2000/ Febrero 2001
Vol. 1 Núm. 6
Editorial
En los últimos meses, el uso de Internet por parte de estudiantes y profesionales de la salud, se ha extendido de manera vertiginosa. Sorprende el entusiasmo existente ante las utilidades presentadas por este nuevo medio. Grupos de discusión, bancos de imágenes, motores de búsquedas, publicaciones electrónicas, educación en línea, son algunos de los recursos que permiten encontrar, rápidamente, data relevante acorde a nuestras necesidades. Una de nuestras tareas más importantes, en estos tiempos, es lograr un adecuado adiestramiento que nos permita identificar, apropiadamente en la red, la información de valor.
Es ampliamente conocido que una gran cantidad de datos biomédicos difundidos por Internet, carecen de arbitraje o supervisión. Esto trae como consecuencia la divulgación de información que podría ser de dudosa calidad. Las...

Agosto-Octubre 2000
Vol. 4 Núm. 5
Arribamos al quinto número de VITAE, luego del primer año de trabajo dedicado desde el ámbito académico, a la divulgación de información biomédica en la red.
Todo un logro del cuerpo de Editores de Area de VITAE, quienes desde sus distintas especialidades, han dedicado parte de su tiempo a materializar los contenidos de valor que en estas cinco ediciones les hemos presentado.
Esto sumado a la excelente labor del equipo del Centro de Análisis de Imágenes Biomédicas Computarizadas (CAIBCO) de la Facultad de Medicina de la Universidad Central de Venezuela, quienes han aportado todo su esfuerzo para darle calidad y continuidad a esta publicación electrónica.
Gracias al resultado de ese mismo esfuerzo, CAIBCO cuenta hoy día con una sede propia, cuya infraestructura está diseñada especialmente para trabajar con los equipos y la tecnología empleados...

Mayo-Julio 2000
Vol. 3 Núm. 4
El presente de las publicaciones electrónicas

Febrero-Abril 2000
Vol. 2 Núm. 3
El Presente de las Publicaciones Electrónicas
El desarrollo de los sistemas de publicación electrónica está transformando, de manera radical, las formas de comunicación de los científicos básicos y clínicos, al proporcionar al lector interactividad, capacidad multimedia y una notable reducción de los costos y de los tiempos de publicación.
En estos tiempos de cambio, son más las interrogantes que las respuestas que existen en torno al impacto que tendrá el formato digital como medio de divulgación del conocimiento, entre ellas : ¿Las publicaciones electrónicas marcarán el fin de las revistas impresas o las complementarán? ¿Qué ocurrirá con los derechos de autor, hasta ahora propiedad de las editorasí ¿Mermarán los ingresos que perciben por suscripción las empresas editorasí Sólo el tiempo se encargará de despejarnos estas y muchas otras...

Noviembre-Enero 2000
Vol. 1 Núm. 2
La revista VITAE Academia Biomédica Digital arriba a su segundo número, producto del trabajo de una serie de profesionales que desde dentro y fuera de la Facultad de Medicina de la Universidad Central de Venezuela, creen en el dinámico medio digital, como vía de discusión y divulgación del conocimiento generado por nuestras casas de estudio. A todos los que contribuyeron nuestros agradecimientos.
Asimismo el Consejo Editorial desea saludar y desear mucho éxito a los nuevos Editores de Area que se incorporan a VITAE, se trata de los Doctores Lucimey Lima (Neurociencias), Hilda Pérez (Inmunología), Hermes Garbán (Medicina Molecular), Gioconda San Blas (Micología) y Martín Rodríguez (Reumatología). Esperamos poder contar a corto plazo con editores en las áreas que hoy no están representadas en esta revista digital.
Es importante destacar el proyecto...

Junio-Agosto 1999
Vol. 1 Núm. 1
Con la presentación de este número inaugural, hoy ponemos a disposición de los profesionales en el área biomédica de Venezuela y la región, una revista con formato digital que hemos llamado \"VITAE Academia Biomédica Digital\", la cual aspiramos se convierta rápidamente en un sitio de referencia obligada para la consulta, discusión y divulgación del dinámico mundo del conocimiento médico .
Este proyecto editorial, viene a sumarse a los logros alcanzados por un equipo multidisciplinario de profesionales altamente calificados, pertenecientes al Centro de Análisis de Imágenes Biomédicas Computarizadas (CAIBCO), de la Facultad de Medicina de la Universidad Central de Venezuela, quienes se propusieron hace 3 años la puesta en funcionamiento de una plataforma de última generación, para el desarrollo de programas avanzados de computación dirigidos al manejo de multimedia...











